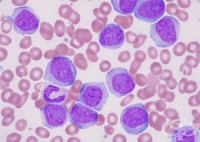

д-р Лилия Пашова-Стоянова
автор във Framar.bg

Д-р Лилия Жечева Пашова-Стоянова, дм, освен в “Медицинска енциклопедия" нa Фрамар, е дългогодишен автор на здравни статии в различни научни списания, вестници и интернет сайтове. Част е от екипа на “Фрамар” от 2016-та година. Като академичен преподавател в университет и автор, нейната мисия е да събуди интереса към науката и медицината в повече хора. Автор е на множество материали, свързани с лекарства, хранителни добавки и лечение на заболявания.
Интереси:
Фармакология, педиатрия, гастроентерология, ендокринология
Рубрики, в които работи:
Участия в български и международни форуми:
- Pashova-Stoyanova L, M.Ganeva. Angiotensin type 1 and angiotensin type 2 receptors in diabetes mellitus. ХХVІ Международна конференция на Съюзa на учените – Стара Загора, 2-3 юни 2016. Постерна Секция Медицина. Програма стр.16
- Пашова-Стоянова Л, Толекова А, Ганева М. Експериментални модели на захарен диабет тип-2 при опитни животни. Научна Конференция „Дръзновение и Младост във Фармакологията“ Цигов чарк, 7-9 октомври, 2016 г.
- Pashova-Stoyanova L., Role of the renin-angiotensin-aldosterone system in diabetes and its complications. ХХVІI Международна конференция на Съюзa на учените – Стара Загора, 1-2 юни 2017. Постерна Секция Медицина. Програма стр. 7
- P. Hadzhibozheva, Ts. Georgiev, N. Genov, L. Pashova, J. Tsokeva, Kr. Nancheva, R. Sandeva, G. Ilieva, A. Tolekova, M. Ganeva; Metabolic disturbances in fructose fed rats and their impact on angiotensin II stimulated contractility of the smooth muscle; гр. Стара Загора, 8-th Bulgarian peptide symposium, June 08 – June 10, 2018
- Росица Сандева, Лилия Пашова-Стоянова, Гергана Сандева, Анна Толекова, Мария Ганева; Дефицитът на витамин Д – риск за хронични, несвързани с костното здраве болести; гр. Сливен, Юбилейна научна конференция „Съвременни тенденции в здравните грижи“, 21-22.09.2018г.
- L. Pashova-Stoyanova, Zh. Tsokeva, Kr. Nancheva, P. Hadzhibozheva, Ts. Georgiev, Vitamin D effects on uric acid in the experimental model of metabolic disorders in fructose fed Wister rats, гр. София, Тринадесета работна среща с международно електронно участие „Биологична активност на метали, синтетични съединения и природни продукти“, 19-21.11.2018
- Pashova-Stoyanova L, Vitamin D effects on lipid profile and uric acid levels in the experimental model of metabolic disorders in fructose fed Wister , Stara Zagora, Faculty of medicine, Trakia University, Experimental models and methods, International scientific symposium, December 17-18, 2018
Курсове:
- Педагогически курс
- Медицински английски език
- Статистически софтуер за обработка на данни – основни методи
- Защита и хуманно отношение към опитни животни, използвани за научни или образователни цели
- Интродукция в биостатистика R
Публикации в сайтове:
Как бързо да отслабна? Отговорът на д-р Линия Пашова-Стоянова
Как се махат пестицидите - съветите на д-р Лилия Пашова-Стоянова
Повече информация за д-р Лилия Пашова-Стоянова
Публикации на автора

C94.5 Остра миелофиброза


Коментари към д-р Лилия Пашова-Стоянова
РАЙКА ХРИСТОВА
ЗДРАВЕЙТЕ!СТРАДАМ ОТ РАЗШИРЕНИ ВЕНИ И БИХ ИСКАЛА ДА ПОПИТАМ МОЖЕ ЛО ЕДНОВРЕМЕННО ДА СЕ ПРИЕМА АСКЕТОН О АСПИРИН ПРОТЕКТ?ПРЕДВАРИТЕЛНО БЛАГОДАРЯ!
Здравейте! Възможно е взаимодействие. Консултирайте се с лекаря си за прием на комбинацията.
ЗДРАВЕЙТЕ!СТРАДАМ ОТ РАЗШИРЕНИ ВЕНИ И БИХ ИСКАЛА ДА ПОПИТАМ МОЖЕ ЛО ЕДНОВРЕМЕННО ДА СЕ ПРИЕМА АСКЕТОН О АСПИРИН ПРОТЕКТ?ПРЕДВАРИТЕЛНО БЛАГОДАРЯ!
Димитър Николаев
Здравейте, В статията за л-тирозин според мен има грешка 150 мг/на килограм тегло е много това прави около 13 грама за 80 килограмов човек по реално ми се струва да е около 15 мг Поздрави
Здравейте! Няма грешка в информацията. Има се предвид дози до 150 мг на килограм тегло.
Здравейте, В статията за л-тирозин според мен има грешка 150 мг/на килограм тегло е много това прави около 13 грама за 80 килограмов човек по реално ми се струва да е около 15 мг Поздрави
Мишо маринов
Здравейте искам да попитам може ли да се проведе терапия от разстояние понеже аз съм в Италия...
Здравейте! Това е информационна страница, а не платформа за връзка.
Здравейте искам да попитам може ли да се проведе терапия от разстояние понеже аз съм в Италия...